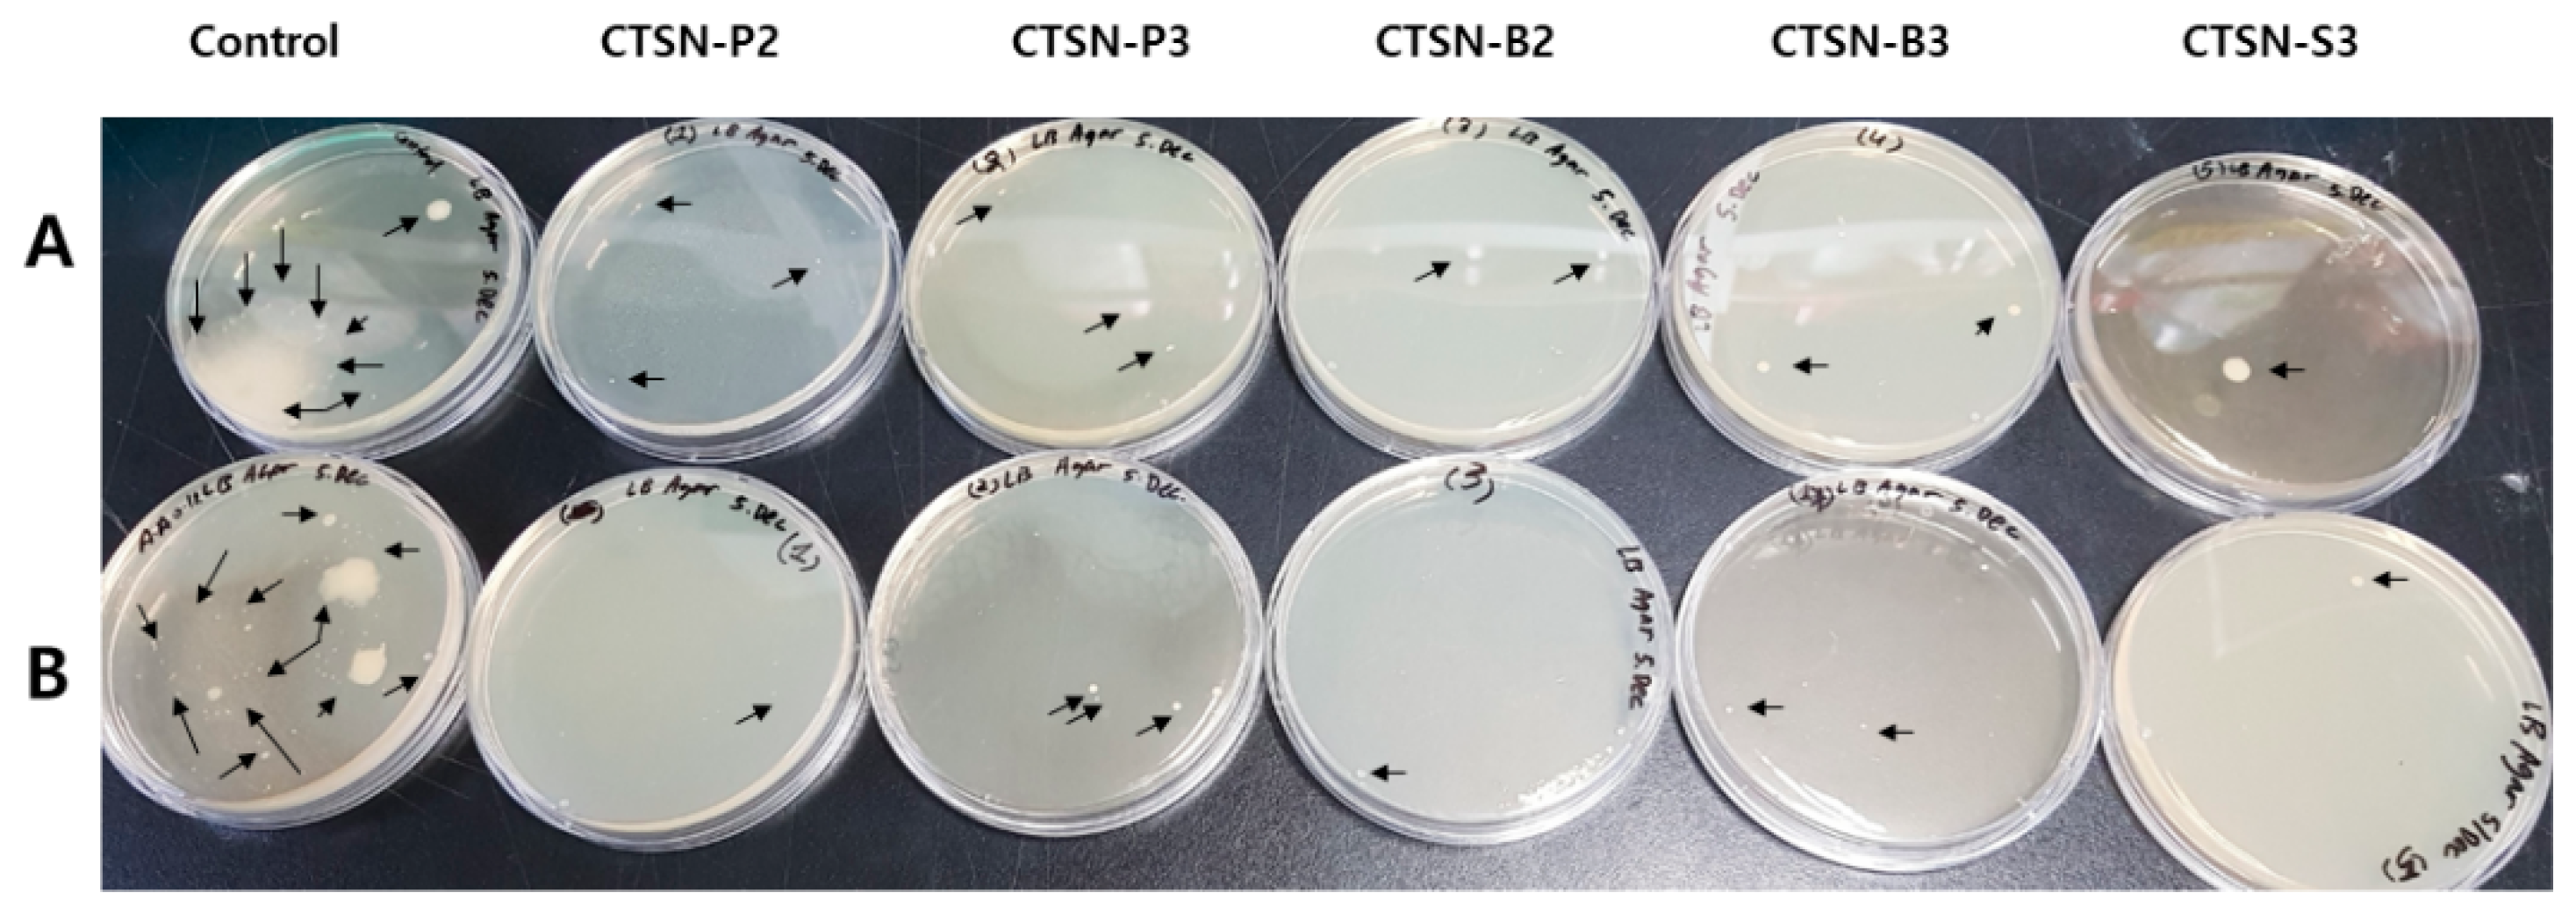
Ijms 20 03085 g002 Ijms 20 03085 g002

Anti-Oxidant Activity and Dust-Proof Effect of Chitosan with Different Molecular Weights
Abstract
1. Introduction
2. Results and Discussion
2.1. Preparation of Chitosan Hydrolysates
2.2. Estimation of Molecular Weight of Chitosan Hydrolysates
2.3. Measurement of Antioxidant Activity
2.4. Removal Effect of Fine Dust and Microorganisms
3. Materials and Methods
3.1. Chemical and Materials
3.2. Preparation of Chitosan Hydrolysates
3.3. Purification of Chitosan Hydrolysates
3.4. Quantification of Chitosan Hydrolysates
3.5. Antioxidant Activity of Chitosan Hydrolysates
3.6. Growth Inhibitory Effect of Chitosan Hydrolysates on Microorganisms
3.7. Removal Effect of Find Dust
4. Conclusions
Author Contributions
Funding
Conflicts of Interest
References
- Fernandes, J.C.; Eaton, P.; Nascimento, H.; Giao, M.S.; Ramos, O.S.; Belo, L.; Santos-Silva, A.; Pintado, M.E.; Malcata, F.X. Antioxidant activity of chitooligosaccharides upon two biological systems: Erythrocytes and bacteriophages. Carbohydr. Polym. 2010, 79, 1101–1106. [Google Scholar] [CrossRef]
- Xie, W.M.; Xu, P.X.; Liu, Q. Antioxidant activity of water-soluble chitosan derivatives. Bioorg. Med. Chem. Lett. 2001, 11, 1699–1701. [Google Scholar] [CrossRef]
- Jia, Z.; Shen, D.; Xu, W. Synthesis and antibacterial activities of quaternary ammonium salt of chitosan. Carbohyd. Res. 2001, 333, 1–6. [Google Scholar] [CrossRef]
- Hosseinnejad, M.; Jafari, S.M. Evaluation of different factors affecting antimicrobial properties of chitosan. Int. J. Biol. Macromol. 2016, 85, 467–475. [Google Scholar] [CrossRef]
- Shen, K.T.; Chen, M.H.; Chan, H.Y.; Jeng, J.H.; Wang, Y.J. Inhibitory effects of chitooligosaccharides on tumor growth and metastasis. Food Chem. Toxicol. 2009, 47, 1864–1871. [Google Scholar] [CrossRef] [PubMed]
- Cheng, M.; Zhu, W.; Li, Q.; Dai, D.; Hou, Y. Anti-cancer efficacy of biotinylated chitosan nanoparticles in liver cancer. Oncotarget 2017, 8, 59068–59085. [Google Scholar] [CrossRef] [PubMed]
- Chien, H.F.; Chen, C.P.; Chen, Y.C.; Chang, P.H.; Tsai, T.; Chen, C.T. The use of chitosan to enhance photodynamic inactivation against candida albicans and its drug-resistant clinical isolates. Int. J. Mol. Sci. 2013, 14, 7445–7456. [Google Scholar] [CrossRef]
- Guo, Z.; Xing, R.; Liu, S.; Zhong, Z.; Ji, X.; Wang, L.; Li, P. The influence of molecular weight of quaternized chitosan on antifungal activity. Carbohydr. Polym. 2008, 71, 694–697. [Google Scholar] [CrossRef]
- Aranaz, I.; Harris, R.; Heras, A. Chitosan amphiphilic derivatives. Chemistry and applications. Curr. Org. Chem. 2010, 14, 308–330. [Google Scholar] [CrossRef]
- Li, H.; Xu, Q.; Chen, Y.; Wan, A. Effect of concentration and molecular weight of chitosan and its derivative on the free radical scavenging ability. J. Biomed. Mater. Res. A 2014, 102, 911–916. [Google Scholar] [CrossRef]
- Salehi, F.; Behboudi, H.; Kavoosi, G.; Ardestani, S.K. Chitosan promotes ROS-mediated apoptosis and S phase cell cycle arrest in triple-negative breast cancer cells: Evidence for intercalative interaction with genomic DNA. RSC Adv. 2017, 7, 43141–43150. [Google Scholar] [CrossRef]
- Hajji, S.; Younes, I.; Rinaudo, M.; Jellouli, K.; Nasri, M. Characterization and in vitro evaluation of cytotoxicity, antimicrobial and antioxidant activities of chitosans extracted from three different marine sources. Appl. Biochem. Biotech. 2015, 177, 18–35. [Google Scholar] [CrossRef] [PubMed]
- Gil-Lozano, C.; Davila, A.F.; Losa-Adams, E.; Fairen, A.G.; Gago-Duport, L. Quantifying Fenton reaction pathways driven by self-generated H2O2 on pyrite surfaces. Sci. Rep. 2017, 7, 43703. [Google Scholar] [CrossRef] [PubMed]
- Ayangbenro, A.S.; Babalola, O.O. A new strategy for heavy metal polluted environments: A review of microbial biosorbents. Int. J. Environ. Res. Public Health 2017, 14, 94. [Google Scholar] [CrossRef] [PubMed]
- Wu, X.; Cobbina, S.J.; Mao, G.; Xu, H.; Zhang, Z.; Yang, L. A review of toxicity and mechanisms of individual and mixtures of heavy metals in the environment. Environ. Sci. Pollut. Res. Int. 2016, 23, 8244–8259. [Google Scholar] [CrossRef] [PubMed]
- Pope, C.A., 3rd; Ezzati, M.; Dockery, D.W. Fine-particulate air pollution and life expectancy in the United States. N. Engl. J. Med. 2009, 360, 376–386. [Google Scholar] [CrossRef] [PubMed]
- Park, J.K.; Chung, M.J.; Choi, H.N.; Park, Y.I. Effects of the molecular weight and the degree of deacetylation of chitosan oligosaccharides on antitumor activity. Int. J. Mol. Sci. 2011, 12, 266–277. [Google Scholar] [CrossRef] [PubMed]
- Pimenta, J.A.; Zaparolli, D.; Pecora, J.D.; Cruz-Filho, A.M. Chitosan: Effect of a new chelating agent on the microhardness of root dentin. Braz. Dent. J. 2012, 23, 212–217. [Google Scholar] [CrossRef]
- Ibrahim, N.A.; Eid, B.M.; El-Aziz, E.A.; Elmaaty, T.M.A.; Ramadan, S.M. Loading of chitosan—Nano metal oxide hybrids onto cotton/polyester fabrics to impart permanent and effective multifunctions. Int. J. Biol. Macromol. 2017, 105, 769–776. [Google Scholar] [CrossRef]
- Zheng, L.Y.; Zhu, J.F. Study on antimicrobial activity of chitosan with different molecular weights. Carbohydr. Polym. 2003, 54, 527–530. [Google Scholar] [CrossRef]
- Tsai, G.J.; Zhang, S.L.; Shieh, P.L. Antimicrobial activity of a low-molecular-weight chitosan obtained from cellulase digestion of chitosan. J. Food Prot. 2004, 67, 396–398. [Google Scholar] [CrossRef] [PubMed]
- Dogra, B.; Amna, S.; Park, Y., 2nd; Park, J.K. Biochemical properties of water soluble polysaccharides from photosynthetic marine microalgae Tetraselmis species. Macromol. Res. 2017, 25, 172–179. [Google Scholar] [CrossRef]
- Lee, C.G.; Koo, J.C.; Park, J.K. Antifungal effect of chitosan as Ca(2+) channel blocker. Plant Pathol. J. 2016, 32, 242–250. [Google Scholar] [CrossRef] [PubMed]
- Chien, P.J.; Sheu, F.; Huang, W.T.; Su, M.S. Effect of molecular weight of chitosans on their antioxidative activities in apple juice. Food Chem. 2007, 102, 1192–1198. [Google Scholar] [CrossRef]
- Tomida, H.; Fujii, T.; Furutani, N.; Michihara, A.; Yasufuku, T.; Akasaki, K.; Maruyama, T.; Otagiri, M.; Gebicki, J.M.; Anraku, M. Antioxidant properties of some different molecular weight chitosans. Carbohydr. Res. 2009, 344, 1690–1696. [Google Scholar] [CrossRef]
- Kim, J.W.; Park, J.K. Synergistic antimicrobial properties of active molecular chitosan with EDTA-divalent metal ion compounds. J. Phytopathol. 2017, 165, 641–651. [Google Scholar] [CrossRef]
- Song, J.Y.; Alnaeeli, M.; Park, J.K. Efficient digestion of chitosan using chitosanase immobilized on silica-gel for the production of multisize chitooligosaccharides. Process Biochem. 2014, 49, 2107–2113. [Google Scholar] [CrossRef]
- Lee, C.G.; Park, J.K. Comparison of inhibitory activity of bioactive molecules on the dextransucrase from Streptococcus mutans. Appl. Microbiol. Biotechnol. 2015, 99, 7495–7503. [Google Scholar] [CrossRef] [PubMed]

| CTSN-P2 | CTSN-P3 | CTSN-B2 | CTSN-B3 | CTSN-S3 | ||
|---|---|---|---|---|---|---|
| Relative activity (%) * | DPPH | 90.78 | 91.27 | 90.81 | 91.59 | 91.07 |
| FRAP | N/D | N/D | N/D | N/D | N/D | |
| ABTS | 17.41 | 21.86 | 17.75 | 24.78 | 20.09 | |
| Av MW (kDa) ** | 31 | 30 | 8.1 | 5.8 | 1.5 | |
| Filter Type | Av MW (kDa) * | Fine Dust Removal Efficiency (%) | |
|---|---|---|---|
| PM 2.5 | PM 10 | ||
| Filter (Control) | - | 48.29 ± 1.41 | 48.68 ± 1.49 |
| Filter + CTSN-P2 | 31 | 62.25 ± 1.92 | 63.49 ± 2.45 |
| Filter + CTSN-P3 | 30 | 56.08 ± 5.14 ** | 57.00 ± 5.26 ** |
| Filter + CTSN-B2 | 8.1 | 57.18 ± 2.62 | 58.27 ± 3.07 |
| Filter + CTSN-B3 | 5.8 | 59.92 ± 4.78 ** | 61.10 ± 5.18 * |
| Filter + CTSN-S3 | 1.5 | 63.13 ± 1.82 | 64.24 ± 1.65 |
© 2019 by the authors. Licensee MDPI, Basel, Switzerland. This article is an open access article distributed under the terms and conditions of the Creative Commons Attribution (CC BY) license (http://creativecommons.org/licenses/by/4.0/).
Share and Cite
Lee, Y.H.; Park, S.Y.; Park, J.E.; Jung, B.O.; Park, J.E.; Park, J.K.; Hwang, Y.J. Anti-Oxidant Activity and Dust-Proof Effect of Chitosan with Different Molecular Weights. Int. J. Mol. Sci. 2019, 20, 3085. https://doi.org/10.3390/ijms20123085
Lee YH, Park SY, Park JE, Jung BO, Park JE, Park JK, Hwang YJ. Anti-Oxidant Activity and Dust-Proof Effect of Chitosan with Different Molecular Weights. International Journal of Molecular Sciences. 2019; 20(12):3085. https://doi.org/10.3390/ijms20123085
Chicago/Turabian StyleLee, Yong Hyun, So Yeon Park, Jae Eun Park, Byung Ok Jung, Jung Eun Park, Jae Kweon Park, and You Jin Hwang. 2019. "Anti-Oxidant Activity and Dust-Proof Effect of Chitosan with Different Molecular Weights" International Journal of Molecular Sciences 20, no. 12: 3085. https://doi.org/10.3390/ijms20123085
APA StyleLee, Y. H., Park, S. Y., Park, J. E., Jung, B. O., Park, J. E., Park, J. K., & Hwang, Y. J. (2019). Anti-Oxidant Activity and Dust-Proof Effect of Chitosan with Different Molecular Weights. International Journal of Molecular Sciences, 20(12), 3085. https://doi.org/10.3390/ijms20123085




